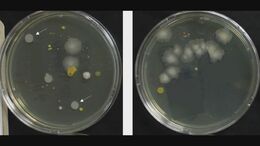
「マスク」ほとんどしなくなった…でもマスクは毎日交換すべき？　マスクの外側に、糞便の中にいる「セレウス菌」検出のケースも|TBS NEWS DIG

「これで引退なんてできない」…病気で議長辞任の自民・細田氏

「任期途中だが、衆議院議長の職を退任したい」
菅氏の不出馬宣言で思い出したのが、その8日前に行われた細田博之前衆院議長(79)の退任会見。脳梗塞の初期で「公務に支障を来す可能性がある。迷惑をかけてはいけない」と議長を退く一方で、「原子力発電やエネルギー問題には非常に強く関与してきた。そういうことはなかなか私以外の人が簡単にできるような仕事じゃない」と次の衆院選にも出馬すると宣言した。
「ちょっと病気になったが、これで引退なんてできない」
地元の漁業関係者と面会した際もこう述べて、議員続投へのこだわりを見せたという。自民党内からは「体調不良を理由に議長を辞任するのに議員は続けますというのでは、国民の理解がなかなか得づらい」(中堅議員)との声が聞こえてくる。
「世襲は国民の参政権を制限している」…政治家の世代交代とは

菅直人氏の後継候補として多くの人が最初に思い浮かべるのは、長男の源太郎さんだろう。
約20年前に岡山1区から衆院選に挑戦した経験があり、現在は菅氏の政策秘書を務めている。
しかし、これも“既定路線”なのだが、菅氏の意中の後継候補は地元選挙区の自治体の首長だという。
なぜ源太郎さんではないのか。
「政治の道を行くことは別に否定しないけれど、我が家ではいわゆる世襲という考え方は望ましくないという発想なのね。世襲というのは、逆に言うと一般の国民の参政権を制限しているわけだよ。民主主義という基本的な土俵の上でそれが広がり過ぎることは望ましいことではないと私自身も思っているよね」
国会論戦の好敵手だった小泉純一郎元総理は「私も3代目の世襲でずいぶん批判されたが、この私の親バカぶりもご容赦いただき、私に賜ったご厚情を進次郎にも頂きたい」と息子に地盤(後援会組織)、看板(知名度)、カバン(資金)の揃った選挙区を引き継いだ。それとは対照的だ。
「歌舞伎とか芸術的なものが引き継がれるとか、分野によっては一概に私も否定しないけども、封建時代じゃないんだから政治が家業みたいになるのはおかしいよ」
世襲でないとしたら、菅氏にとって望ましい後継者はどんな人なのだろうか。
「後継者を選ぶのは有権者なんだから、私がこういう人が特にいいとか言ったら、それはまた世襲みたいになる。でも、私がコテコテの保守のほうに変わるはずがないんでね。やっぱり、色々政党名は変わったけど、大体私の路線はリベラルなやや革新的なというところでずっと一貫してるから、その流れを踏襲してくれる人であれば応援しやすいよね」